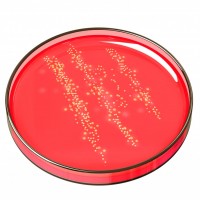

Using the word “gatekeeper” is getting me into a bit of trouble lately. I see why. It’s a loaded image—one that suggests control for the sake of control; power as an object rather than a means. But the truth is, the recent history of the interpretive environment surrounding the serious arts is to some extent a story of control and power. As I wrote in my last post, the history of sacralization … [Read more...]
Archives for February 2014
Raising Up the Masses?
In the launch to this blog on January 27, I asserted a hyphothesis: the more audiences are invited to participate in social interpretation the more sophisticated and adventurous arts consumers they will become. This hypothesis is based on an observable problem and a proposed solution. The problem: It is widely agreed that we’ve been delivered into a live + digital world where we expect to be … [Read more...]
The Only Thing New in the World is the History You Don’t Know
It may be hyperbolic, but there’s something important embedded in this oft-quoted Harry Truman line. For me, studying the past (and analyzing it) is a way of thinking. And when we think with history, to evoke cultural historian Carl Schorske, we learn to apply the complexities of the past as a means for orienting ourselves to the complexities of the present. So here’s the history lesson: social … [Read more...]